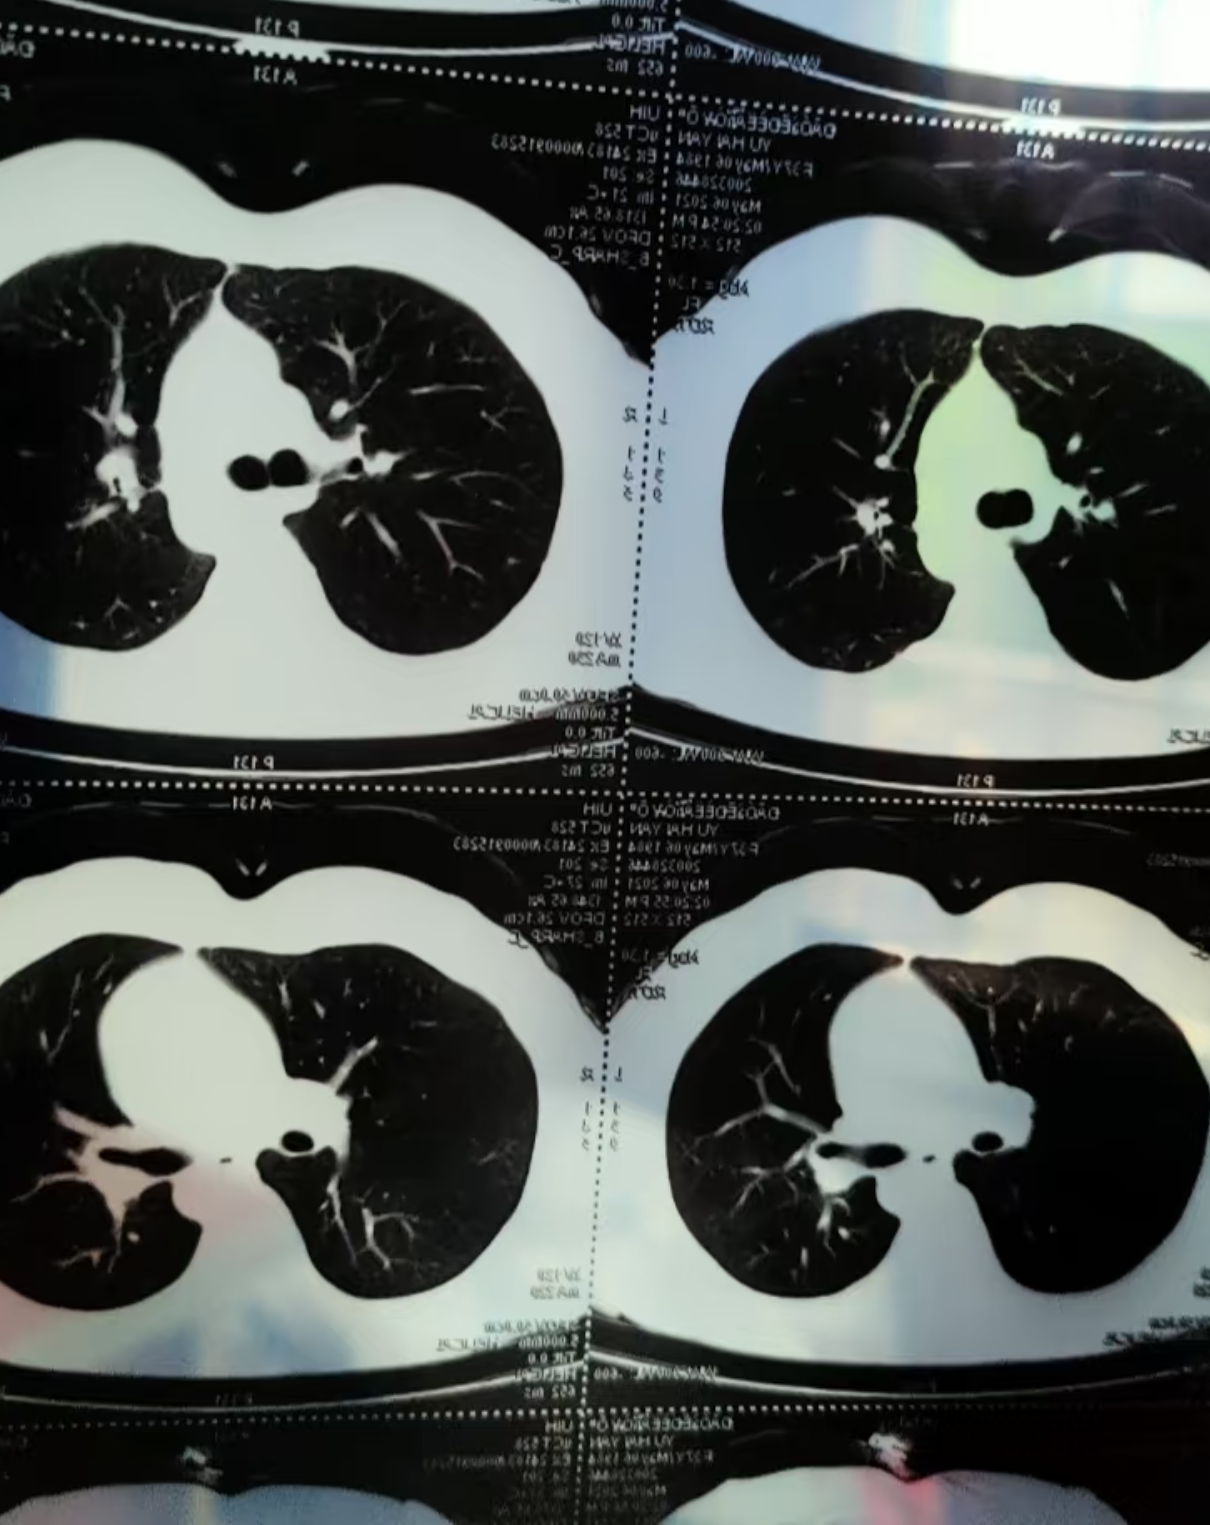
肺部有结节严重吗

肺结节是肺部出现的直径小于或等于3厘米的圆形或椭圆形病灶,可能是炎症结核或肿瘤引起的如果发现肺结节,需要医生根据具体情况评估是否需要进一步检查和治疗 抢首赞 评论 分享 举报 为你推荐特别推荐 电动车多次降价,品质是否有保障? 什么是“网络厕所”?会造成什么影响? 华强北的二手手机是否靠谱? 癌症的治疗费用为何越来越高?等你来答。
肺部结节本身不存在“严重”的绝对定义,其严重程度需结合结节大小特征及患者症状综合判断结节直径小于8毫米时若结节边界清晰形态规则,且患者无咳嗽胸闷气喘痰中带血或体重下降等临床症状,通常属于低风险结节此类结节多为良性病变,如炎症后遗留的瘢痕肉芽肿或良性肿瘤如错构瘤处理。
肺结节是通过肺部影像学检查发现的直径小于等于3cm的类圆形或不规则形病灶,其严重程度需结合病因治疗时机综合判断病因与严重性关联肺结节本身无传染性,多数患者无症状,常在体检时偶然发现其严重性主要取决于病因1若由肺部真菌感染肺腺瘤样增生肺错构瘤等良性病变引起,及时治疗如抗真菌药。
总结肺内微小结节的严重性取决于其大小形态位置及患者高危因素良性结节占比高,但特定情况下需警惕恶性可能及时就医规范随访和健康管理是关键。
肺部结节的严重程度需综合判断,不能一概而论,其严重性主要与结节特征及患者高危因素相关结节大小是关键指标小于5毫米的结节多为良性,通常建议定期复查胸部CT如每612个月一次以监测变化若结节大于8毫米,尤其是短期内明显增大,或直径超过15毫米,恶性风险显著升高,需进一步检查形态与影像。
肺上2cm的结节是否严重不能一概而论,需结合结节特征患者病史及身体状况综合判断结节特征方面2cm的结节属于较大结节,恶性可能性相对较高若结节形状不规则边缘不清晰或有分叶,或为实性结节或部分实性结节含磨玻璃成分,需高度警惕恶性可能此外,倍增时间结节增长速度也是评估性质的。
肺里有结节并不一定很严重,其严重程度需综合多方面因素判断从结节本身来看肺结节分为实性结节和亚实性结节包括部分实性结节和纯磨玻璃结节多数肺结节为良性,例如由肺部感染如细菌病毒结核分枝杆菌等感染引起的结节,在感染得到控制后,部分结节可缩小或消失但也有部分肺结节可能是。
肺部结节的严重程度需综合评估,多数情况下不严重,但需警惕恶性可能具体判断需结合以下因素结节大小直径小于5毫米的微小结节多为良性,尤其是首次发现且无高危因素者,通常建议定期复查如每612个月一次若结节直径超过8毫米,尤其是持续增大者,恶性风险显著升高,需进一步检查形态特征边缘。
肺里有微小结节不一定严重,其严重程度取决于结节性质多数肺微小结节为良性病变肺微小结节指直径小于5mm的结节,常见成因包括肺部炎症或感染愈合后留下的瘢痕组织,以及长期吸入粉尘等刺激物导致的局部反应这类结节生长缓慢,通常不会对肺部功能造成显著影响,患者也往往无明显症状对于此类良性结节。
肺结节的严重性需结合结节性质大小生长速度及伴随症状综合判断具体分析如下若肺结节为良性且无症状,严重性较低此类结节多由肺部炎症陈旧性损伤或结核等非恶性因素引起,形态规则生长缓慢,通常不会对肺功能造成显著影响患者可能无明显不适,仅在体检时偶然发现治疗上以定期复查为主,通过。
有肺部基础疾病史者如肺结核需考虑结核复发或瘢痕可能,但也不能排除新发恶性病变有肺癌家族史者恶性风险相对增加,需更密切监测和全面检查总结肺部微小结节的严重程度需结合性质特征及人群特点综合判断良性结节通常不严重,但需规范随访恶性结节需尽早干预发现结节后,应通过专业检查明确性质,并遵循医生建议进行个体化管理。
肺部多发性结节是否要紧,需根据结节性质判断良性结节通常不要紧若肺部多发结节以良性病变为主如炎症后遗留的瘢痕肉芽肿错构瘤等,通常不会对健康造成严重威胁这类结节生长缓慢,形态规则,边缘清晰,无恶性特征如毛刺征分叶征患者可能无明显症状,仅需定期复查如每612个月进行低。
多数肺部结节为良性病变,常见原因包括炎症结核或肉芽肿等这类结节通常体积较小,边缘光滑,无显著症状,一般不严重医生通常会建议定期复查CT,动态观察结节是否缩小消失或保持稳定,以排除恶性可能若结节存在以下特征,需警惕恶性可能结节体积较大直径超过8毫米的结节恶性风险显著升高形态不。
性别本身不是判断肺结节严重程度的直接决定因素,但在肺癌发病情况中,男性肺癌发病率通常高于女性长期吸烟有长期接触石棉放射性物质等职业暴露史的人群,肺结节恶性的风险更高有肺癌家族史的人群,其肺结节恶性的概率相对高于无家族史的人群有肺部基础疾病如慢性阻塞性肺疾病肺纤维化等的患者。
发现肺部有结节的严重程度不能一概而论,需综合多方面因素判断若结节为良性,通常不严重例如肺部感染后遗留的炎性结节肺错构瘤等,这类结节生长缓慢,对肺部功能和身体健康影响较小,患者可能无任何症状对于此类情况,一般只需定期复查,观察结节变化即可,无需过度担忧若结节具有恶性特征,则。
右肺下叶小结节的严重程度需综合判断,多数情况下不严重,但存在恶性可能,需根据具体情况分析若结节直径较小如小于5mm,且边缘光滑密度均匀,通常为良性病变这类结节可能是肺部既往感染如肺炎肺结核愈合后遗留的纤维灶,或肺内淋巴结,一般无需特殊治疗,定期随访观察即可若结节直径较大。
肺部结节的严重程度需综合评估,不能简单判定结节大小是初步判断的关键指标直径小于5毫米的结节多为良性,恶性概率较低,病情相对不严重,通常建议定期复查如每612个月进行一次胸部CT以观察变化直径在510毫米的结节,恶性风险有所增加,需结合其他特征进一步评估,可能需进行增强CT或PETCT检查。
肺部微小结节的严重性不能一概而论,需结合以下因素综合判断1 结节大小直径小于5毫米的结节定义为微小结节,通常恶性可能性较低,但需定期复查如首次检查后3个月6个月12个月复查观察变化若结节直径超过10毫米,恶性风险显著增加,需进一步检查2 结节形态良性结节多表现为边缘光滑规则。
转载请注明来自极限财经,本文标题:《肺部有结节严重吗》

京公网安备11000000000001号
京公网安备11000000000001号 京ICP备11000001号
京ICP备11000001号
还没有评论,来说两句吧...